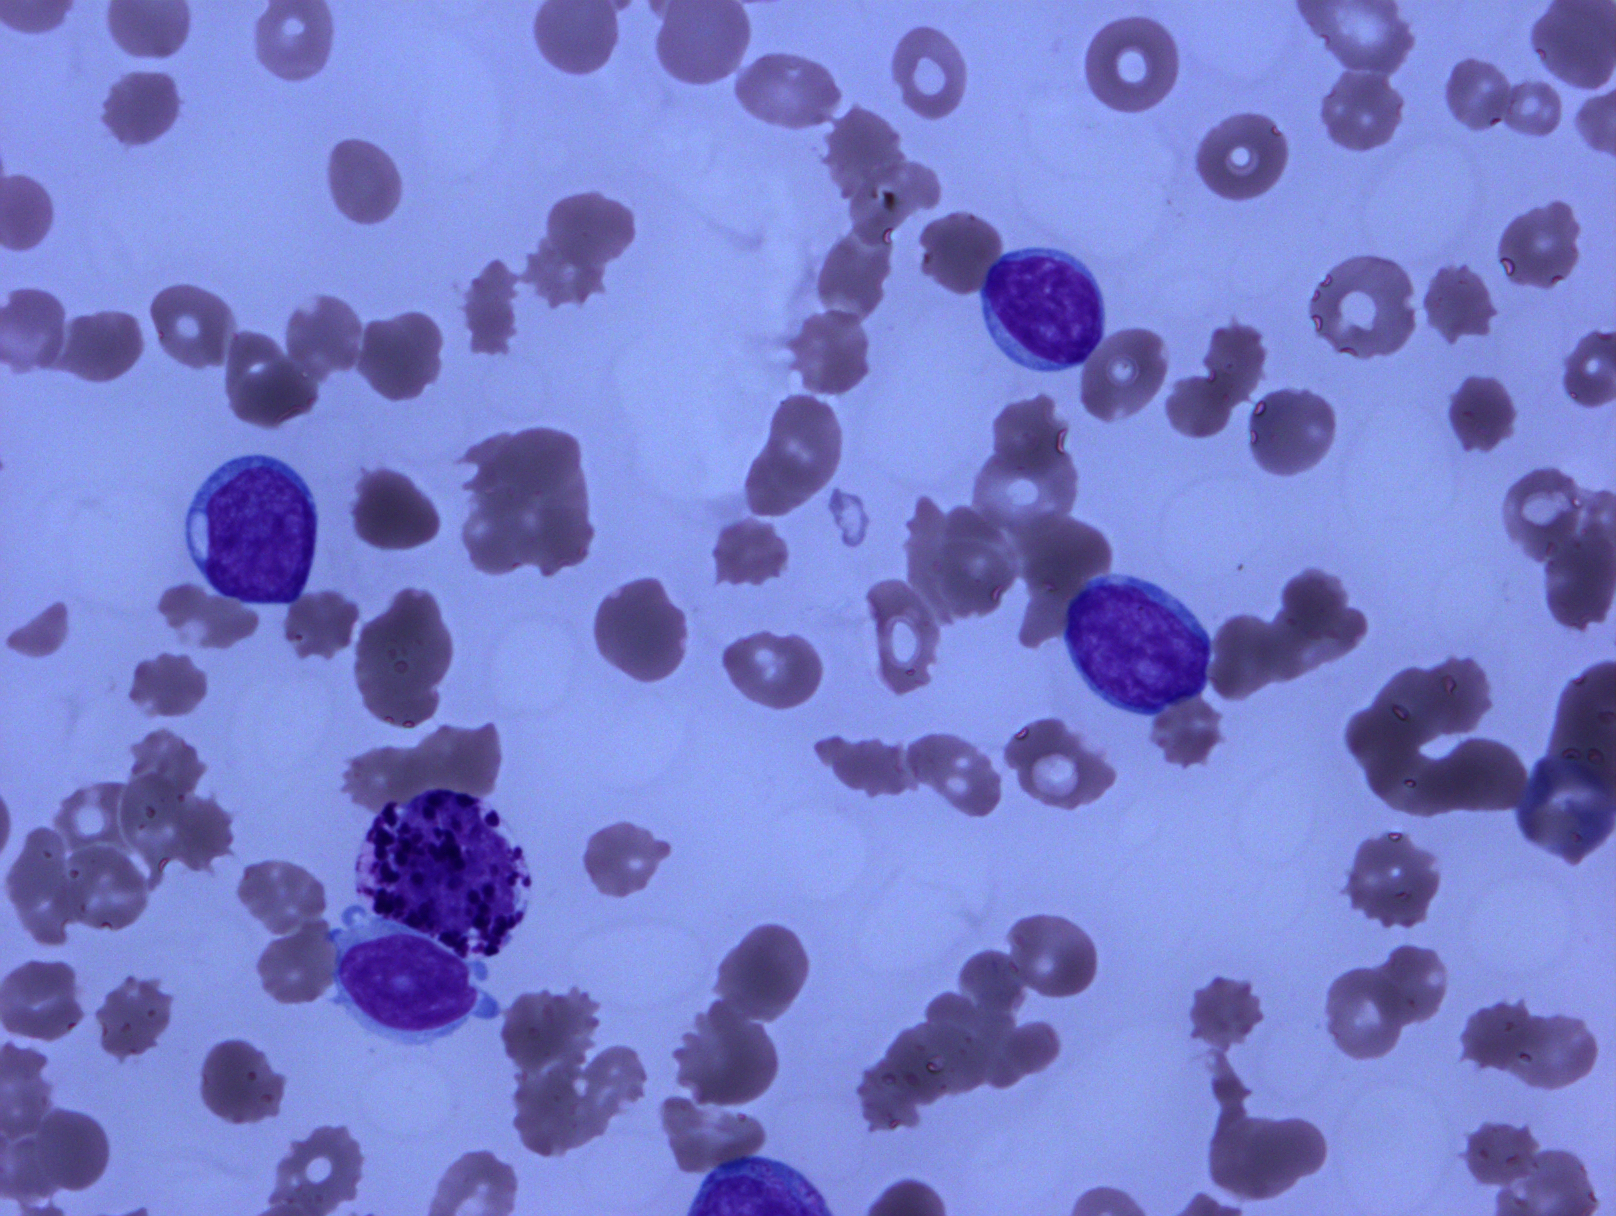

慢性髓系白血病,BCR-ABL1 阳性
Chronic Myeloid Leukemia (CML), BCR-ABL1 Positive
概述:
慢性髓系白血病是起源于多能干细胞的骨髓增生性肿瘤,其发病与位于 Philadelphia 染色体上的 BCR-ABL1 融合基因有关。其自然病程分为一开始的慢性期(Chronic Phase, CP)和随后的加速期(Accelerate Phase, AP)及母细胞期(Blast Phase, BP)。
诊断要点:
任何年龄均可发病,中位年龄 40-50 岁,男性稍多。临床表现为乏力、体重减轻、盗汗、贫血、脾大;部分病例无症状,常规体检查血时发现。如不治疗,多数患者从慢性期进展为加速期再到母细胞期,也有的从慢性期突然进入母细胞期,甚至一开始就表现为母细胞期。
各期共同形态学和遗传学特征:粒细胞及其前体细胞增高(母细胞计数不等),噬碱粒细胞增高,血小板高,t(9;22)(q34;q11)或其变异型染色体异位,或/和 BCR-ABL1 融合基因阳性(p210. p230. p190)。
慢性期形态学特征及诊断标准(2017 年版 WHO)
外周血:
白细胞增高,12-1000X109/L(中位值 80X109/L),以中幼粒细胞和分叶核粒细胞为主;
部分病例血小板增高(p230),少数病例仅表现为血小板增高;
原始细胞< 2%,嗜碱性粒细胞绝对数增多,单核细胞一般不高(< 3%),但少数病例增高(p190)
- 骨髓:
细胞密度/增生程度通常显著增高(> 95%);仅表现为血小板增高的病例细胞密度可正常或轻度增高;
粒系增生明显至极度活跃, 骨小梁周围不成熟细胞常增加到 5-10 个细胞的宽度(正常只有 2-3 层);
成熟谱系类似外周血,原始细胞< 5%,红系减少;
巨核系可以减少,但 40-50%病例巨核系可显著增多,以分叶少、单个核、体积小(“侏儒型”)为特征;
嗜酸细胞、嗜碱细胞常增多,经常见到高雪细胞;
30-40%的病例网状纤维增加伴巨核细胞增多,并与脾肿大相关。
- 加速期:符合下列任何 1 项血液学/细胞遗传学标准 a 或对 TKI 反应的临时标准即可诊断加速期(2017 年版 WHO):
血液学/ 细胞遗传学标准 a
① 持续或进行性白细胞增多(>10×109/L),且治疗无效;
② 持续或进行性脾肿大,治疗无效;
③ 持续血小板增多(>1000×109/L),且治疗无效;
④ 持续血小板减少(<100×109/L),治疗无效;
⑤ 外周血嗜碱粒细胞 ≥20%;
⑥ 外周血和/或骨髓原始细胞 10%~ 19%b、c;
⑦ 初诊时 Ph 阳性细胞有另外克隆性染色体异常,包括所谓的主通路异常(如第二个费城染色体、8 号染色体 3 体、17q 等臂染色体,19 号染色体 3 体),复杂核型、3q26.2 异常;
⑧ 治疗过程中 Ph 阳性细胞出现任何新的克隆性染色体异常。
对 TKI 反应的临时标准
① 血液学对第一个 TKI 抵抗(或未获完全缓解 d)
② 任何血液学、细胞遗传学或分子显示对连续 2 个 TKI 抵抗
③TKI 治疗过程中发生 2 个或更多 BCR-ABL1 融合基因突变。
※a.骨髓活检中大的簇状或片状分布小巨核细胞伴显著网状纤维或胶原被认为是 AP 的证据,这些证据常和其他一种或多种上述列表中的改变伴随出现。
※b.外周血或骨髓中明显的淋巴母细胞(即使<10%)应警惕快速淋巴母细胞转化,需要进一步临床及遗传学检查。
※c. 外周血或骨髓原始细胞 ≥20%或髓外原始细胞增生浸润应诊断为 CML 母细胞期。
※d.完全血液学缓解的标准:血白细胞计数<10×109/L,血小板<450×109/L, 无未成熟粒细胞,脾脏不能触及。
- 母细胞期:母细胞期的诊断标准包括(符合其中之一即可诊断):
① 外周血或骨髓原始细胞 ≥20%(一些学者或临床试验采用原始细胞 ≥30%为母细胞期的诊断标准,但不管采用哪个诊断标准,大多数母细胞期患者预后不良)。骨髓活检标本中原始细胞局部片状分布占据一定的面积,如 1 个完整的小梁间区或更大,即使其它区域仍表现为慢性期也要确定为母细胞期的证据;
② 髓外原始细胞增生浸润。最常见于皮肤、淋巴结、骨、中枢神经系统,其它任何部位均可发生。
免疫表型特征
大多数母细胞期病例的原始细胞为髓系,包括中性粒、单核、巨核、嗜碱粒、嗜酸粒、或者红系、或者以上任何形式的组合。
20-30%母细胞期患者原始细胞为淋巴母细胞(通常为 B 淋巴母,但也有 T 淋巴母和 NK 细胞的报道)。
髓系母细胞期的原始细胞 MPO 表达可以很强,也可以弱表达甚至不表达,但表达 1 种或多种粒、单核、巨核或红系分化抗原,如 CD33. CD13. CD14. CD11b、CD11c、CD117. CD15. CD41. CD61. CD235a、CD235b。
很多髓系母细胞期病例,原始细胞也表达 1 种或多种淋巴细胞相关抗原。
多数淋巴母细胞转化病例为 B 淋巴母源性,除表达 CD19. CD10. CD79a、PAX5. CD20 等 B 细胞相关抗原外,还表达 TDT。少数病例为 T 淋巴母源性,表达 CD2. CD3. CD5. CD7. CD4. CD8 等 T 细胞相关抗原。
淋巴母细胞期病例常表达 1 种或多种髓系相关抗原,也可见双系来源(明显的髓系细胞群和淋系细胞群),也有序贯发生 B 淋巴母和髓系母细胞转化的病例报道。
近期研究显示 TKI 治疗后发生少见母细胞类型转化的病例不断增加,如原始嗜碱粒细胞、原始巨核细胞等。
慢性期 CD34 阳性细胞表达 CD7 为预后不良因素,而 CD34 阳性细胞群比例正常、不表达 CD56. CD7 或 CD11b 等异常标记预示对 TKI 治疗敏感。
遗传学
90-95%病例都有特征性的 t(9;22)(q34.1;q11.2),其余病例表现为涉及第 3 个甚至第 4 个染色体变异型异位或其变异型染色体异位,或 9q34.1 与 22q11.2 隐性异位(常规染色体检查不能发现,需要 FISH 或 RT-PCR 检测)。
根据 BCR 基因的不同断裂点部位,产生三种大小不同的融合基因蛋白:p210. p190. p230,p230 型常显示中性粒细胞明显分化成熟和/或血小板增多,而 p190 型常与单核细胞增多相关。
80%病例在 AP 或 BP 转化时显示除 ph 染色体外的染色体异常,包括另外 Ph 染色体、+8. +19. i(17q)等,CML 初诊时有上述任何染色体异常提示预后不良,故将这些病例划分为 AP 期。
AP 及 BP 转化过程中常涉及基因突变,包括 TP53. RB1. MYC、CDKN2A(p16INK4a)、NRAS、KRAS、RUNX1(AML1)、TET2. CBL、ASXL1. IDH1 和 IDH2,但这些基因突变在转化过程中的作用还有待进一步研究。
预后
未接受有效治疗的病人大多数于 3-5 年转化为 AP、BP。TKI 治疗 CML 预后的最重要影响因素是在血液学、细胞遗传学和分子水平对 TKI 治疗的抵抗。第一代 TKI 治疗遗传学完全反应率为 70-90%,5 年无进展和总生存率为 80-95%。二代 TKI 治疗可更快更高比例获得分子水平缓解。TKI 治疗时代很少 CML 患者死于白血病,总体生存率和无白血病人群近似。

鉴别诊断:
- 慢性中性粒细胞白血病 :外周血白细胞持续性增高 (至少达 25 x 10⁹/L),其中 80% 为分叶和杆状中性粒细胞,不成熟粒细胞<10%,无发育异常;骨髓粒系增生,巨核细胞无明显增多,各系无发育异常,无“侏儒型”巨核细胞。绝大部分病例有 CSF3R 突变,无t(9;22) (q 34;q 11) 或其变异型染色体异位,BCR-ABL1 融合基因阴性。
- 不典型慢性粒细胞白血病** ,BCR-ABL 阴性:外周血白细胞持续性增高(至少 13 x 10⁹/L),其中不成熟粒细胞(早幼粒、中幼粒、晚幼粒)至少 10%,并有发育异常;骨髓粒系增生伴发育异常。部分病例有 SETBP1 突变,无t(9;22) (q 34;q 11) 或其变异型染色体异位,BCR-ABL1 融合基因阴性。
- 慢性粒-单核细胞白血病 :外周血持续性单核细胞增高至少达 1 x 10⁹/L,并同时有外周血或骨髓一系或多系发育异常,或有克隆性细胞/分子遗传异常,但无t(9;22) (q 34;q 11) 或其变异型染色体异位,BCR-ABL1 融合基因阴性。
- 反应性粒细胞增高/类白血病反应 : 有相应病史,如感染。外周血粒系增高,可有核左移,常有中毒性改变,噬碱粒细胞不高,中粒细胞碱性磷酸酶活性正常。无t(9;22) (q 34;q 11) 或其变异型染色体异位,BCR-ABL1 融合基因阴性。
